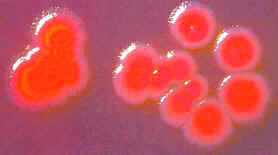
Bacteria Escherichia coli

| Natureduca - Portal educativo de ciencia y cultura |


Cocina y gastronomía
HIGIENE Y MANIPULACIÓN DE ALIMENTOS
Riesgos para la salud derivados del consumo de alimentos - 2ª parte
Enfermedades alimentarias por microorganismos y sus toxinas
Enfermedades bacterianas
as bacterias
son microorganismos que existen en la naturaleza en gran número y en todos
los ambientes imaginables, desde las altas montañas hasta grandes
profundidades submarinas, desde medios alcalinos hasta ácido de pH casi
igual a cero, en aguas termales o heladas, etc.

Las
bacterias son microorganismos que existen en la naturaleza en gran
número y en todos los ambientes imaginables. Las hay beneficiosas y
también perjudiciales para la salud de humanos y animales.
Las enfermedades bacterianas que merecen especial atención cuando se trata de la manipulación de alimentos, son las siguientes:
Salmonelosis
La salmonela se encuentran en el intestino del hombre y de los animales, y también en la cáscara de huevo.
La presencia en los alimentos se debe a malas prácticas de manipulación, como falta de higiene personal, falta de limpieza de los equipos y útiles de trabajo, así como la falta de tratamiento térmico (la salmonela se destruye a temperaturas superiores a 65°C) . Los alimentos implicados son principalmente la carne de aves, huevo y ovoproductos, salsas y derivados, coco, pastas, etc.La salmonelosis es la causa de más de la mitad de las intoxicaciones alimentarias al año en nuestro país. El hombre como fuente de salmonela es importante debido a la posibilidad de actuar como portador, es decir, padecer la enfermedad y transmitirla sin que aparezcan sin tomas.
Esta enfermedad se caracteriza por presentarse con síntomas digestivos, y aparece a las 6-72 horas después de la ingestión del alimento contaminado.Listeriosis
Está producida por Listeria monocitogenes. Los alimentos implicados son los quesos frescos, leche no pasterizada, productos del mar y carnes. Esta bacteria es importante ya que resiste el calor y las bajas temperaturas además de sales y la acidez. La sintomatología es variada, incluso abortos, y aparecen a las 48-72 horas.
Estafilococia
Esta enfermedad está provocada por la toxina elaborada por Staphylococcus aureus. Esta bacteria se encuentra ampliamente distribuida, siendo su localización habitual la piel de hombre y animales, así como la zona de nariz, boca y garganta. También la encontramos en los forúnculos y heridas infectadas, de ahí que sea importante la higiene por parte de los manipuladores ya que el hombre es la principal fuente de contaminación de los alimentos.
Al igual que ocurría con la salmonelosis también existen portadores. Los alimentos implicados son carnes, leche, queso, productos de pastelería, ensaladas, huevos, etc. La bacteria se destruye por acción del calor, pero su toxina resiste estos tratamientos.Esta enfermedad cursa con sintomatología digestiva y aparece a las 2-4 horas de la ingestión del alimento contaminado.
Diarrea coliforme
Está provocada por las toxinas elaboradas por Escherichia coli, siendo la principal causante de enfermedades alimentarias la cepa 0157:H7.
Bacteria
Escherichia coli
Se caracteriza la enfermedad por alteraciones digestivas con diarreas sanguinolentas.
Botulismo
Está provocada por la ingestión de toxina producida por Clostridium botulinum. La bacteria se encuentra en el suelo y a partir de aquí puede pasar a los alimentos, así los alimentos implicados son generalmente verduras y hortalizas (maíz, judías verdes, espárragos, etc.).
La enfermedad se asocia a las conservas, ya que es en ellas donde se va a producir la toxina, esta toxina puede resistir temperaturas superiores a los 100°C, y otra característica es que necesita ausencia absoluta de oxígeno, de ahí que también pueda aparecer en los alimentos envasados al vacío. Es característico que las latas de conservas aparezcan abombadas y al abrirlas expulsen gas.La toxina botulínica es una de las toxinas naturales más potentes que se conocen, provocan una parálisis respiratoria y así la muerte.
Shigelosis
Esta enfermedad se conoce con el nombre de "enfermedad de las manos sucias". Los alimentos implicados son las carnes crudas, aves, leche y productos lácteos. Los alimentos se contaminan cuando el manipulador no se lava las manos correctamente y tiene contacto con alimentos o útiles.
Provoca una enfermedad digestiva más grave que la salmonelosis, incluso con hemorragias.Clostridium perfringens
Este germen está muy distribuido por el medio ambiente y en ocasiones está presente en alimentos. Tiene la característica de producir toxinas en alimentos que ya han sido cocinados, y así el peligro se presenta durante el enfriamiento y almacenamiento de alimentos preparados.
Las carnes y sus derivados son los alimentos más frecuentemente implicados, también pueden aparecer en especias. Es importante mantener los alimentos calientes a las temperaturas correctas, por encima de los 65° C.La sintomatología es de tipo digestivo, y aparece a las 8 - 12 horas de la ingestión.